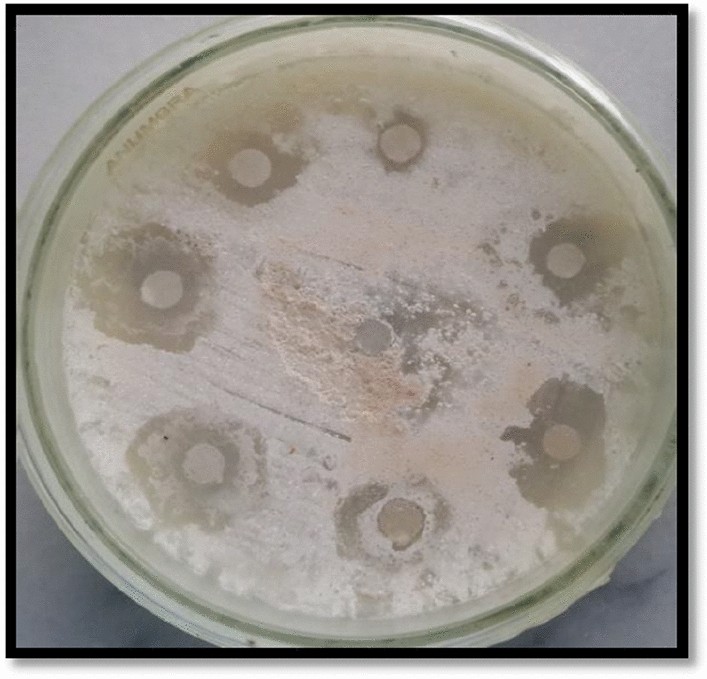
Figure 7

Figure 7

Protein kinase inhibition activity of F. cretica crude extracts and its ZnO nanoparticles. α-Amylase inhibition activity.
Protein kinase inhibition activity of F. cretica crude extracts and its ZnO nanoparticles. α-Amylase inhibition activity.